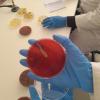
Uspješno obavljena praksa studenata Odsjeka za biologiju Prirodno-matematičkog fakulteta UNSA u Zavodu NALAZ
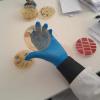
Uspješno obavljena praksa studenata Odsjeka za biologiju Prirodno-matematičkog fakulteta UNSA u Zavodu NALAZ

Uspješno obavljena praksa studenata Odsjeka za biologiju Prirodno-matematičkog fakulteta UNSA u Zavodu "NALAZ"

Ponedeljak, Juli 8., 2024. - 14:12
Uspješno je obavljena praksa studenata IV godine smjera Mikrobiologija Odsjeka za biologiju Prirodno-matematičkog fakulteta Univerziteta u Sarajevu u Zavodu za biomedicinsku dijagnostiku i ispitivanje "NALAZ". Studenti su upješno položili i testove, a ovom prilikom su im uručeni primjerci knjige “Bakteriologija”, autora akademkinje prof. dr. Mirsade Hukić i saradnika, kao nagradu za izuzetne rezultate.
Izuzetnu zahvalnost upućujemo direktorici Zavoda "NALAZ" akademkinji prof. dr. Mirsadi Hukić i mentorima prakse Anesu Šljivi i Adisi Ramić.